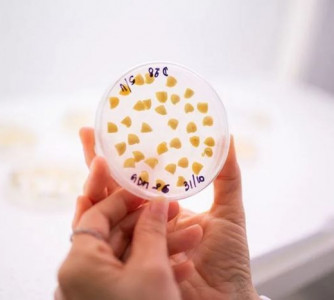

Matérias-primas
Notícias sobre as matérias-primas do biodiesel
Segurança alimentar
FAO: Preços dos óleos vegetais tiveram alta forte em julho
BiodieselBR.com
Soja
Chuvas nos EUA, apesar de insuficientes, pressionam soja em Chicago nesta 2ª
Notícias Agrícolas
Soja
Soja
Brasil bate recorde de 18 anos na exportação de óleo de soja
Fábio Rodrigues
Soja